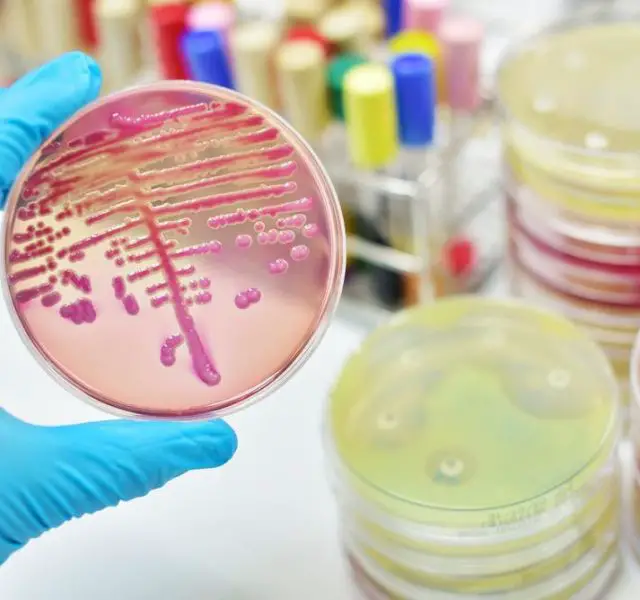

Chlamydia

Contents
What is Chlamydia?
Chlamydia (misspelled as clamidia, chlamidia, clamydia, clymidia, chlymidia, clamidia, chlamidia, etc.) is a common curable bacterial sexually transmitted disease (STD). Chlamydia trachomatis, or simply chlamydia, is an infection caused by pathogen bacterium that can afflict the cervix in women and the urethra and rectum in both men and women. Occasionally other parts of the body (lining of the eyelid, throat and rectum) can be affected.
More than 90 million cases of Chlamydia are reported each year globally with more than a half occurred in women. The highest rate of infections is observed among teens and young adults. About half of men and most women infected with chlamydia trachomatis do not observe any symptoms which leads to the disease being untreated and easily passed from partner to partner. Chlamydia can be cured easily with simple antibiotics otherwise serious complications can occur in the reproductive system such as PID and even infertility.
How is it Contracted?
Chlamydia is transmitted primarily through sexual activity. The following are the most common ways:
- unprotected intercourse (vaginal, anal) with an infected partner
- oral sex, although a less common cause of infection as bacteria Chlamydia trachomatis targets the genital area rather than the throat. Although it is possible theoretically, the cases of infestation from mouth-to-penis and penis-to-mouth contact are rare
- vagina, cervix, anus, penis or mouth contacting infected secretions or fluids which means that contraction can occur even if the penis or tongue does not enter the vagina or anus
- bacteria can travel from the vaginal area to the anus or rectum of women while wiping with toilet paper
- sharing sex toys
- from mother to the newborn during vaginal childbirth through the infected birth channel
- infection can be transferred on fingers from the genitals to other parts of the body (for example, chlamydia can occur in the eyes)
Chlamydia is not contracted through simple kissing, handshaking, any casual contacts, sharing baths, towels and cups as well as from toilet seats.

Chlamydia trachomatis, an obligate intracellular human pathogen, is one of four bacterial species in the genus Chlamydia. 3D illustration
Incubation Period of Chlamydia
7–21 days.
Signs and Symptoms of Chlamydia
Chlamydia is known as one of the ‘silent’ diseases which can produce no symptoms for a long period of time. Approximately 70–95 percent of women and 50 percent of men with chlamydia do not observe chlamydia symptoms at all. The symptoms can also be mild and almost unnoticeable.
Another reason why symptoms are not the best way to determine the infection is that it is often confused with gonorrhea as the symptoms are very much alike. Asymptomatic nature of chlamydia makes it difficult to estimate how long a person remains infectious and this period is commonly believed to last until full recovery.
Chlamydia symptoms show up between 1 and 3 weeks after the contraction.
Chlamydia Symptoms in Women:
- unusual or abnormal vaginal discharge, sometimes yellowish and smelly
- painful and frequent urinating
- bleeding between periods or heavy periods
- painful sex or bleeding after sex
- pain in the lower abdominal sometimes with nausea and low-grade fever
- swelled skin inside the vagina or around the anus
Chlamydia Symptoms in Men:
- white/cloudy, watery discharge from the tip of the penis
- painful urinating
- testicular pain and/or swelling
- swollen skin around the anus
Depending on the localization of the infection, women, men and children may experience inflamed rectum, urethra or eyelids. The symptoms of mouth and throat infections are rare although a person can suffer a sore throat. Eyes infected with chlamydia can be itchy, swelled, cause painful sensations or produce discharge similar to conjunctivitis. Infection in the rectum results in bleeding, chlamydia discharge and pain.
Testing of Chlamydia
Testing is the only reliable way to find out if the person is infected. The new generation of tests is accurate and easy to take. Swab tests taking samples of the cells and fluid from the penis, cervix, urethra or anus and urine test are among the options.
Swab test is obtained by briefly placing a swab in the opening of the urethra at the tip of the penis; this causes brief discomfort and a burning sensation. For men the swab is taken from the opening of the urethra at the tip of the penis which causes a burning feeling. However, this type of test is overly more reliable than urine testing.
Treatment of Chlamydia – Is there a Cure for Chlamydia?
Chlamydia can be cured easily and effectively with simple antibiotics (e.g. azithromycin and doxycycline) once it has been diagnosed. The treatment can consist of a single dose or last up to 2 weeks depending on the type of chlamydia. The infected person should not have penetrative sex until receiving a negative Chlamydia test at an after-treatment check-up. Both partners must be treated for chlamydia and undergo re-testing after 3–4 months.
Treatment of Chlamydia:
- Doxycycline 100 mg 2–3 times a day for 10–14 days, or
- Zithromax® (azithromycin)0 gm (4 x 250 mg) a single dose, or
- Zithromax® Z-pak®(azithromycin) — 500mg on day 1, followed by 1 tab (250mg) once a day for 4 more days
Patients being treated for chlamydia are often treated for gonorrhea as well because the symptoms are similar and a person can be infected of both (about 50% of patients suffer both diseases together).
Treatment of Gonorrhea:
- Cipro® XR500 mg a single dose, or
- Levaquin®500 mg a single dose, or
- Tequin®400 mg a single dose.
Herb remedies for Chlamydia
Rules for Successful Treatment
The patient should make sure that the doctor is informed if the patient is pregnant or has any allergies. These conditions influence the choice of the medicine prescribed. No matter which antibiotic the patient takes treating chlamydia the following points should be remembered:
- The treatment of all partners on the infected person is obligatory
- Abstain from sex contacts during the treatment and until the negative result on chlamydia test is received
- It is unadvisable to interrupt the course of antibiotics treatment as it will result in the necessity to start again from the beginning. Although the symptoms may disappear, the infection may still remain in the body
- It is necessary to get tested after 3–4 months after the end of the treatment to make sure the infection is no longer in the body.
Complications of Disease
Due to its asymptomatic nature chlamydia infection is often left undiagnosed and goes untreated which may result in spreading to womb and fallopian tubes and cause serious damage and even long-term health problems.
In women untreated chlamydia can lead to pelvic inflammatory disease, an infection damaging the reproductive organs (uterus and fallopian tubes) and in some cases requiring hospital treatment. The possible dangerous effects of the PID are:
- ectopic pregnancy (a pregnancy outside the womb)
- blocked fallopian tubes (the tubes which carry the egg from the ovaries to the womb), which can result in reduced fertility or infertility
- long term pelvic pain
- early miscarriage or premature birth

Trachoma of the eye. Progression of trachoma. Trachoma, an infection of the eye caused by Chlamydia trachomatis. Trachoma is a bacterial infection that affects your eyes
Among the Other Consequences of Untreated Chlamydia Are:
- Cystitis (inflammation of the urinary bladder)
- Mucopurulent cervicitis, an inflammation of the cervix with yellowish vaginal discharge and pain during sexual intercourse
In Men Untreated Chlamydia Can Lead to:
- Epididymitis — painful inflammation of the inner structures of the testicles, which may cause reduced fertility or sterility. A rare complication of Epididymitisis reactive arthritis, which causes pain in the inflamed joints that can be disabling
- Prostatitis
- Occasionally, Reiter’s syndrome (arthritis, inflammation of urethra and eyes)
- Urethritis — inflammation of the urethra with a yellow discharge appearing at the tip of the penis. Untreated urethritis results in narrowing of the urethra which leads to painful urinating and can cause kidney problems
Chlamydia Infection Prevention
To avoid the risk of getting the infection the following can be done:
- Abstain from sex contacts (vaginal, oral and anal) or limit the number of sex partners
- Use condoms during every intercourse and from the very beginning of the contact until the last skin contact (necessary as chlamydia is contracted even if the penis or tongue does not fully enter the vagina or anus)
- Make sure your new sexual partner is uninfected (encourage them to get tested) or follow monogamous life
- Avoid using water-based spermicides as nonoxynol-9 found in most of them is not effective in combatting the risk of chlamydia transmitting
- Get tested regularly if you have active sexual life and often change partners
Preventing the spread of Infection
It is absolutely necessary to inform the partner (or all partners) if you get a positive test for Chlamydia. The sooner the partner is told the more effective and simple the treatment can be. Make sure your partner gets tested and receives the treatment as well and abstain from the intercourse until the treatment of both you and the partner is finished.
Chlamydia and Pregnancy
There is a risk of passing chlamydia from the pregnant infected woman to her baby during delivery which makes it obligatory to treat the disease during the pregnancy. The treatment is absolutely safe with the right antibiotics prescribed by the doctor.